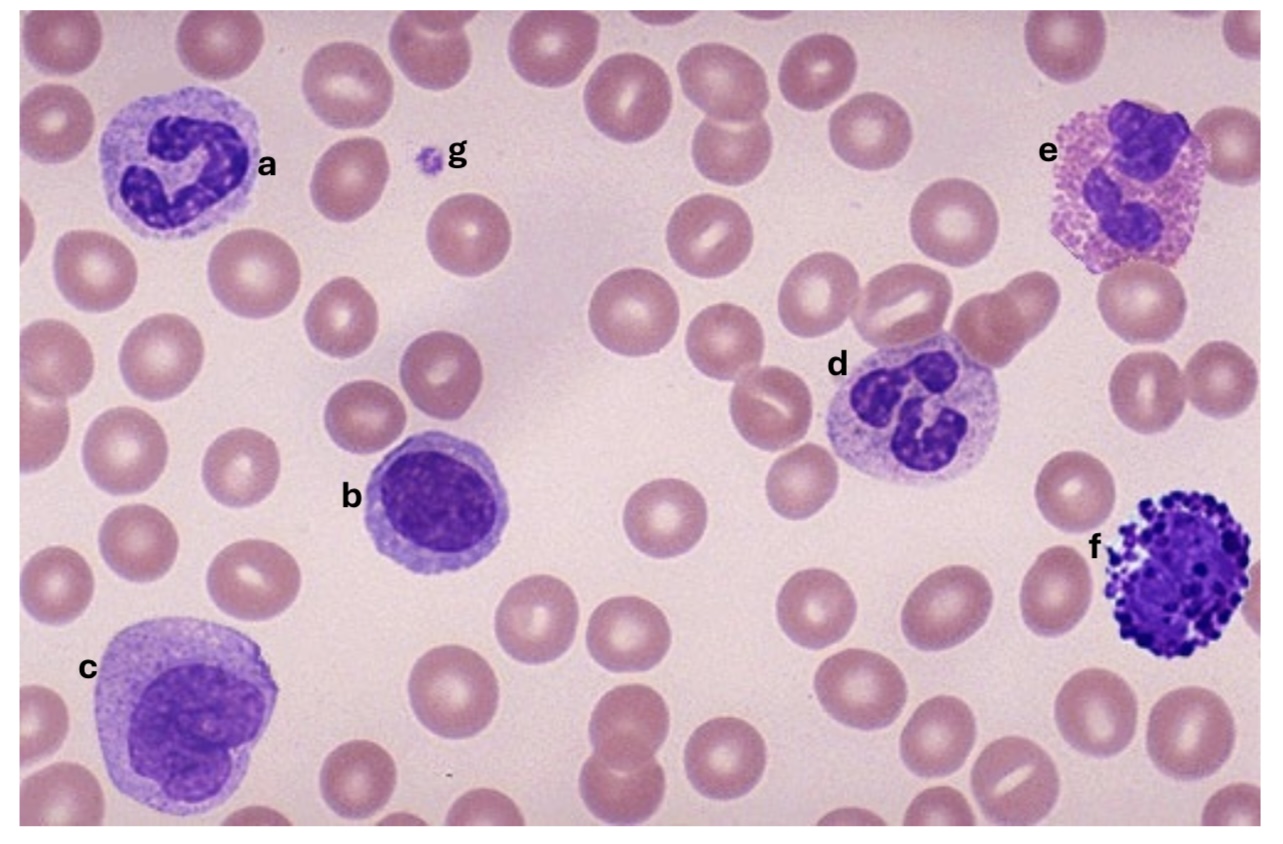
<p>Label the cells A-G</p>

1/8
Looks like no tags are added yet.
Name | Mastery | Learn | Test | Matching | Spaced | Call with Kai |
|---|
No analytics yet
Send a link to your students to track their progress

A. ID the epithelium
B. ID the type of epithelium
C. ID the labeled structure
D. ID the labeled structure
E. Name two sites where you could find this kind of transition between two types of epithelium
A. Stratified squamous
B. Simple columnar
C. GALT
D. Junction between rectum and an*s
E. Esophageo-cardiac junction, anorecta junction

A. ID the specific organ
B. ID the labeled region
C. ID the labeled structure
D. ID the labeled structure
E. ID the labeled tissue and the specific region and glands is in.
A. Duodenum
B. Lamina propria
C. MALT
D. Lamina muscularis mucosa
E. Submucosal mucus-secreting glands within the tunica submucosa

A section taken at the base of an intestinal gland.
A. Name the labeled cell
B. Name the labeled cell
C. Name the labeled cell
D. What does the cell in (C) secrete?
A. Endocrine cell
B. Goblet cell
C. Paneth cell
D. Secretes antimicrobial peptides and proteins

ID as many cell types as you can
enterocytes, goblet cell, plasma cell, lymphocyte, eosinophil

A. ID the system this section is taken from
B. ID the cell
C. ID the structure
D. ID the labeled structure
E. ID the structure and function
A. Digestive system
B. Plasma cell
C. Lamina muscularis mucosa
D. Blood vessel
E. Submucosal ganglion; it acts on LMM to increase secretion of the intestinal glands

A. ID the segment of the GIT
B. Name all the cell types and the predominant cell type
A. Colon, rectum
B. Enterocytes, goblet cells

A. Classify the gland, B. Classify the gland, C. Name the labeled part, D. Name the mode of secretion
A. Simple coiled tubular/ melocrine, apocrine
B. Simple acinar / Holocrine
C. Ducts
D. Holocrine
Label the cells A-G
A. Band neutrophil
B. Lymphocyte
C. Monocyte
D. Segmented neutrophil
E. Eosinophil
F. Basophil
G. Blood platelet

A. ID the specific type of blood cell
B. What is the labeled structure?
C. Name contents of the granules within the cytoplasm?
A. Segmented neutrophil
B. Barr body
C. Peroxidase, acid hydrolase, neutral proteases, elastase, lysoszumes, etccc